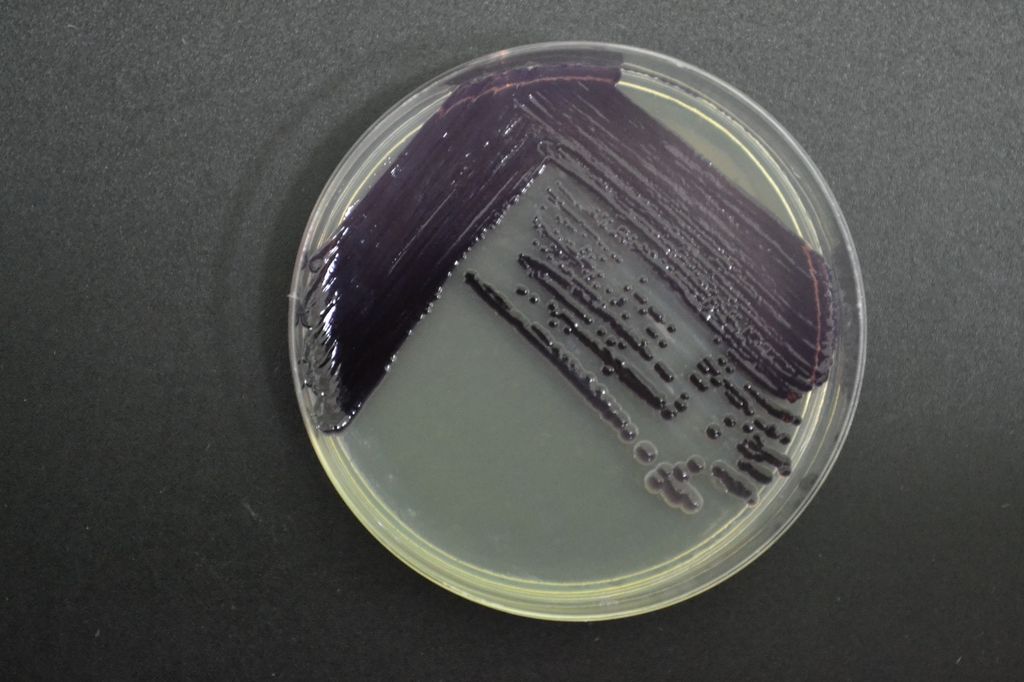
WhatsApp Image 2024-12-04 at 13 WhatsApp Image 2024-12-04 at 13

4 de diciembre de 2024
Investigación chilena abre camino para la producción de bioplásticos antibacterianos y antioxidantes a partir de una bacteria nativa de la Patagonia
En el marco de la realización de su tesis doctoral, el investigador Mario Sepúlveda caracterizó una bacteria nativa de la Patagonia para la biorefinería de compuestos de alto valor con potenciales aplicaciones en biomedicina por sus propiedades antibacterianas y antioxidantes.
En el marco de su tesis doctoral, el investigador Mario Sepúlveda realizó avances significativos en la producción de bioplásticos y compuestos de alto valor a partir de bacterias nativas, ofreciendo una solución innovadora y sostenible para aplicaciones en salud. Este proyecto fue desarrollado al alero del Núcleo Milenio BioGEM, el Doctorado en Biotecnología de la Universidad Técnica Federico Santa María (UTFSM) y la Pontificia Universidad Católica de Valparaíso (PUCV). La investigación fue liderada por Mario Sepúlveda, quien realizó su tesis bajo la dirección del Dr. Michael Seeger, director del Núcleo Milenio BioGEM.
La investigación se centra en la biorefinería de Janthinobacterium sp. BmR6b, una bacteria nativa de la Patagonia, que ha demostrado ser una fuente prometedora para obtener el bioplástico biodegradable polihidroxibutirato (PHB) y el pigmento violaceína, ambos con potenciales aplicaciones biomédicas. “Las bacterias nativas son una fuente de compuestos de alto valor como el PHB y la violaceína, que poseen propiedades antibacterianas y antioxidantes y podrían ser utilizados en aplicaciones de ingeniería de tejidos y biomedicina”, explica Mario Sepúlveda, quien obtuvo el grado de Dr. en Biotecnología gracias a este estudio.
El PHB es un bioplástico biodegradable y biocompatible, ideal para aplicaciones en las que se requieren materiales sostenibles y funcionales, desde empaques hasta dispositivos médicos. Además, al integrar la violaceína, un pigmento con capacidades antibacterianas y antioxidantes, se obtiene un bioplástico que no solo es biodegradable, sino que también podría ofrecer protección contra microorganismos de alta relevancia clínica.
El objetivo de la investigación fue “determinar las bases moleculares de la síntesis de polihidroxibutirato (PHB) y violaceína en Jantinobacterium sp. BmR6b para establecer la producción simultánea de ambos compuestos en biorreactor y evaluar la integración de PHB y violaceína producidos por la cepa BmR6b para obtener un bioplástico antibacteriano”, explicó Mario Sepúlveda.
Gracias a la colaboración con la Dra. Francisca Acevedo, directora Alterna de BioGEM y académica de la Universidad de la Frontera, con amplia experiencia en la técnica de electrohilado o electrospinning, el equipo creó andamiajes (scaffolds) de microfibras a partir de PHB y violaceína. Estos andamiajes pueden emplearse en la regeneración de tejidos, el cuidado de heridas y diversas aplicaciones biomédicas y otros campos.
Al respecto, el Dr. Michael Seeger señala: “Estos andamiajes se pueden funcionalizar agregando compuestos bioactivos, como la Janthinobacterium, que es capaz de producir la violaceína. La violaceína, por ejemplo, aporta propiedades antimicrobianas y antioxidantes que ayudan a proteger el andamiaje, evitando infecciones y el estrés oxidativo, lo cual resulta valioso en la regeneración de tejidos y el tratamiento de heridas”.
En síntesis, los principales hallazgos del estudio fueron: “Establecer las condiciones de cultivo para la coproducción, logrando integrar estos dos compuestos y evitando que la bacteria Staphylococcus aureus se adhiera a estos andamiajes, comprobando que la presencia de la violaceína reducía este riesgo de contaminación. El otro hallazgo importante fue demostrar que bacterias nativas como la Janthinobacterium, que se encuentra en la región de Magallanes, tiene aplicabilidad para generar procesos biotecnológicos de alto valor”, precisó Mario Sepúlveda.
La biorrefinería desarrollada en este estudio explora un concepto en el que se busca maximizar los productos de valor en un solo proceso, inspirada en el modelo de refinación del petróleo, pero aplicado a recursos de base biológica y biodegradables.
Este trabajo no sólo ofrece una alternativa sostenible a los plásticos convencionales, sino que también representa un gran avance en el campo de la economía circular, potenciando el uso de recursos naturales propios del país. Al integrar el conocimiento científico con la valorización de la biodiversidad local, BioGEM contribuye a la creación de biotecnologías de alto valor para la industria y la sociedad chilena, realizando investigación pionera integrando la innovación y la sustentabilidad en beneficio de la salud humana y el medioambiente.

